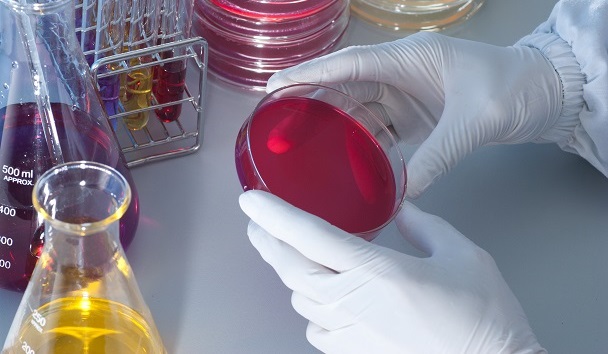
Nuevas Carreras en la Universidad Central del Ecuador

La educación online ha revolucionado la forma de acceder a la educación superior, ofreciendo una alternativa flexible y accesible a estudiantes de todo el país. En Ecuador, las […]
Las mejores universidades online gratis en Ecuador
En la era digital, la educación online se ha convertido en una alternativa accesible y de calidad para aquellos que buscan ampliar sus horizontes académicos. Ecuador no se […]
¿Qué universidades son gratuitas en Ecuador?
El acceso a la educación superior gratuita es un derecho fundamental en Ecuador, y el Estado ecuatoriano ofrece diversas opciones para que los estudiantes puedan cursar sus estudios […]
Nuevas Carreras en la Universidad Central del Ecuador
La Universidad Central del Ecuador (UCE), fiel a su compromiso de ofrecer una formación integral y actualizada a las necesidades del país, ha incorporado cinco nuevas carreras a […]
¿Qué carrera tiene más futuro en Ecuador?
El futuro del mercado laboral en Ecuador es complejo y dinámico, por lo que es difícil determinar con precisión qué carrera tiene el «más futuro». Sin embargo, existen […]
¿Dónde estudiar Ensamblaje y Mantenimiento de Equipos de Cómputo?
El Ensamblaje y Mantenimiento de Equipos de Cómputo es una carrera técnica que te permite adquirir los conocimientos y habilidades para ensamblar, configurar, diagnosticar y reparar computadoras de […]
¿Dónde estudiar Marketing Digital y Negocios en Ecuador?
El Marketing Digital y los Negocios son dos áreas que se complementan perfectamente en el mundo actual. Si te apasiona el mundo digital y te interesa convertirte en […]
¿Dónde estudiar Desarrollo de Software en Ecuador?
El desarrollo de software es una carrera con una alta demanda en el mercado laboral actual, tanto en Ecuador como en el mundo. Si te apasiona la tecnología […]
¿Dónde estudiar Electromecánica Automotriz en Ecuador?
La electromecánica automotriz es una carrera técnica que combina conocimientos de mecánica, electrónica y electricidad para el diagnóstico, reparación y mantenimiento de vehículos modernos. Si te apasiona el […]
¿Dónde estudiar Diseño de Interiores en Ecuador?
El Diseño de Interiores es una carrera apasionante que te permite transformar espacios en lugares funcionales, estéticos y confortables. Si te apasiona este campo y deseas convertirte en […]
¿Dónde estudiar Redes y Telecomunicaciones en Ecuador?
Las Redes y Telecomunicaciones son una rama fundamental de la ingeniería que juega un papel vital en el mundo actual. Si estás interesado en una carrera en este […]
Cursos de Ciberseguridad en Ecuador
En la era digital, la ciberseguridad se ha convertido en una necesidad fundamental para individuos y organizaciones. Ecuador no es la excepción, y la demanda por profesionales capacitados […]